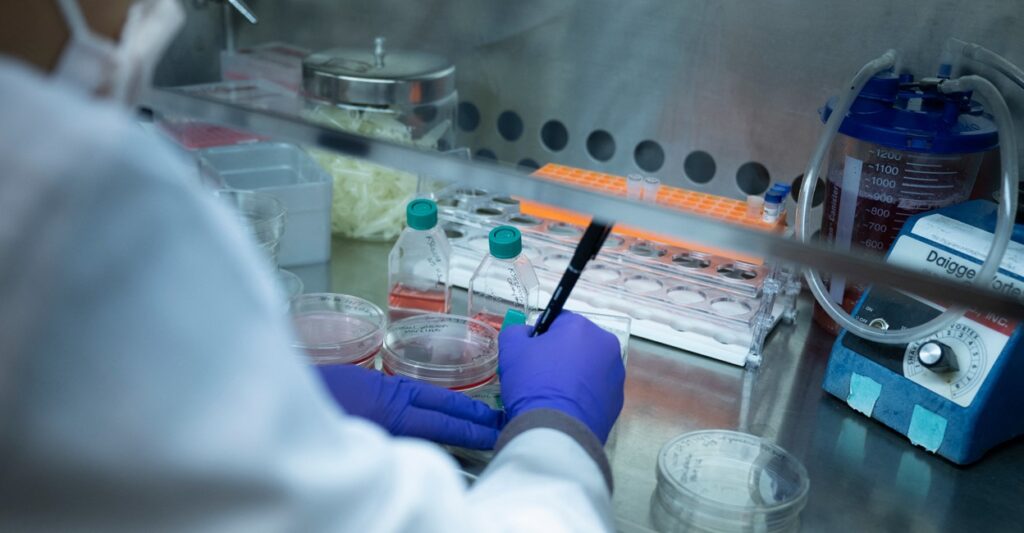
A lab technician writes down results from a test in a laboratory.

Over the weekend, the National Institutes of Health announced that it would be cutting the rate at which it pays universities for overhead on federal research grants from an average of about 60% to 15%. Not surprisingly, there were howls of protest from university staff and their fellow-travelers in the media. Given their professional commitment to the truth, it is surprising to see how false and misleading those objections have been.
The biggest whopper came from a Washington Post story covering the NIH announcement with the headline: “NIH cuts billions of dollars in biomedical funding, effective immediately.” But the NIH didn’t cut a penny from the amount it would spend. It simply limited how much of its funding could go to administrative overhead. Spending the same amount but capping overhead costs actually increases the net amount available for biomedical research. A more accurate headline would have been, “NIH cuts billions in administrative expenses, allowing more to be spent on biomedical research.”
Defenders of 60% overhead rates, however, insist that they absolutely need this money to cover things like the costs of buildings, research labs, electricity, and janitorial staff that research projects require but that are not directly listed as expenses in a research grant. Even if it were true that some research expenses cannot be itemized, waving your hands at the need for buildings and janitors does not prove that you need 60 cents for every dollar spent on research to cover those costs.
The truth is that no one knows exactly how much overhead on research costs. Universities supposedly calculate their costs and negotiate a rate with the federal government, but university finances are opaque and easily manipulated to inflate the overhead rate. And the federal government doesn’t bother to haggle over giving someone else’s hard-earned money to their buddies in academia.
While we don’t know the true rate for overhead, we have many reasons to believe that it is nowhere near 60%. Universities act like it is impossible to produce research with less than a 60% rate for overhead, but they have managed to produce research with much lower overhead rates in the past. The historic rate universities charged for overhead was as low as 8% following World War II and has typically been less than half what it is now. The costs of research and overhead have certainly gone up over time, but there is no reason why overhead should consume a significantly larger portion of the total expense. Did the costs of buildings and janitors rise more than twice as fast as the costs of researchers?
In addition, if the overhead rate is supposed to cover fixed costs that cannot be allocated to individual research projects, it should be the case that overhead rates would go down as research funding went up. But the opposite is true. Overhead rates have risen as the government has massively increased spending on research. And universities that receive significantly more research funding actually charge higher overhead rates than institutions getting less funding. Overhead cost rates are driven more by accounting shenanigans than economies of scale.
The claim that a 60% overhead rate is absolutely necessary is also undermined by the fact that universities regularly accept research grants from private foundations that pay 15% or less for overhead. If universities can manage to do research for George Soros or Bill Gates for little or no overhead, maybe they can do it for taxpayers for a lot less than 60%.
There is also the problem that universities often get donors to pay for the fixed costs of buildings and research labs. Asking taxpayers to cover those same expenses a second time creates an unaccountable slush fund that administrators can use to advance their personal ambitions or political agendas. In fact, we observe that for every $100 million universities receive in overhead, they hire an additional 15.5 people to work as diversity, equity, and inclusion bureaucrats.
Capping the overhead rate makes research spending more accountable. Classifying an expense as overhead simply means that the expense is not itemized in the grant so that the university does not have to demonstrate that the money is spent on that specific thing. Some expenses that are not currently itemized could be if the cap limited the non-itemized amount to 15%. For example, universities could charge research projects rent for their lab space or allocate a fraction of shared equipment to different projects. Legitimate costs could still be covered but forcing more of them to be itemized would protect taxpayers from having their money siphoned off for DEI or other unnecessary nonsense.
Even if capping overhead at 15% left some fixed costs uncovered, it is also the case that research generates benefits for universities that justify those expenditures. For example, universities that get more federal funding enjoy enhanced reputations that help them recruit faculty and students and raise money from donors, which can be worth significantly more than any loss on the fixed cost of research. Universities also have missions to advance research, which federal funding helps them accomplish even if taxpayers don’t cover every last dime.
It is unseemly that universities with billions in endowments are hounding taxpayers to pay for every pencil and administrator partially devoted to producing research. And these rich institutions, concentrated in coastal cities, are often using the war chests provided by overhead to snap up promising researchers from universities in flyover states to create research monopolies to extract even more from hard-working taxpayers.
Yes, ordinary taxpayers can benefit from medical research breakthroughs, but they already pay quite a lot to pharmaceutical companies and hospitals for those innovations. They don’t need to pay another fortune to universities sitting on billions in endowments and rich enough to indulge radical nonsense.